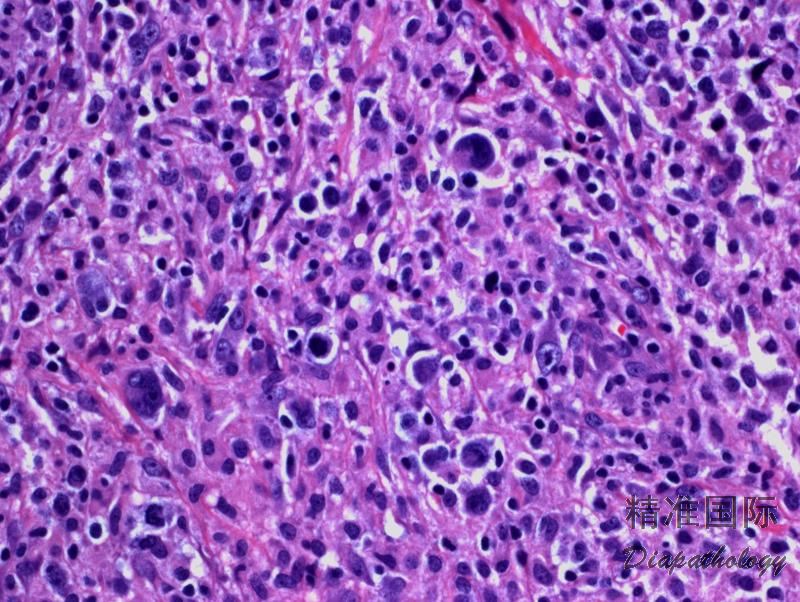

结节硬化型经典型霍奇金淋巴瘤
Nodular Sclerosis Classical Hodgkin Lymphoma, NSCHL
概述:
何杰金淋巴瘤(Hodgkin lymphoma, HL)是一种来源于单克隆 B 细胞的肿瘤,分为结节性淋巴细胞为主型霍奇金淋巴瘤(nodular lymphocyte predominant Hodgkin lymphoma, NLPHL)和经典型霍奇金淋巴瘤(classical Hodgkin lymphoma, CHL)。后者又分为四种组织学亚型:结节硬化型经典霍奇金淋巴瘤(NSCHL)、淋巴细胞丰富型经典霍奇金淋巴瘤(LRCHL)、混合细胞型经典霍奇金淋巴瘤(MCCHL)、淋巴细胞消减型经典霍奇金淋巴瘤(LDCHL)。 CHL 的组织学共同特征是少量的 Hodgkin 细胞(单核)或 Reed-Sternberg 细胞(多核)散在分布于大量的反应性背景细胞中,它们包括淋巴细胞、嗜酸细胞、粒细胞、浆细胞和组织细胞及不等量胶原纤维。 NSCHL 表现为显著纤维化和胶原束围绕分隔形成肿瘤细胞结节,其中有很多陷窝细胞(lacunar cells),系 Hodgkin 细胞和 Reed-Sternberg 细胞的变异形态。
诊断要点:
最常见的亚型,发病高峰年龄为 15-34 岁。常见部位为纵隔和颈部淋巴结。
正常淋巴结结构消失,代之以胶原束围绕分隔的大小不等的肿瘤结节,其中含 HRS 细胞和陷窝细胞(lacunar 细胞)及大量小淋巴细胞、嗜酸细胞、粒细胞等炎性细胞。
Reed-Sternberg 细胞体积大、多核或单个大分叶核,核膜清楚,核染色质淡,可见显著嗜酸性核仁;胞质丰富,嗜双色性。Hodgkin 细胞为单核变异型,核大,含显著嗜酸性核仁,常有核周空晕;胞质强嗜酸性。陷窝型细胞主要见于此亚型(NSCHL),系福尔马林固定导致胞质收缩形成的陷窝状空隙,核常分叶,核仁明显(但总体上,与其它 CHL 相比,NSCHL 的 HRS 细胞核较易分叶,叶较小,核仁也较不突出)。形态上可以有变异型(见下)。
免疫组化:肿瘤细胞 CD30+(>95%),CD15+ (70-80%),PAX5+(弱),MUM-1+,CD20-/+, OCT2-/+,BOB1-,EBER-/+,CD79a- (10%+),CD45-,EMA-,ALK-。
变异型:
合胞体变异型 NSCHL: 肿瘤细胞或 lacuna 细胞集结成片,多形性增加,常伴坏死。此变异型的主要意义在于有可能误诊为大细胞淋巴瘤如间变大细胞淋巴瘤、弥漫大 B 细胞淋巴瘤或转移癌。
纤维组织细胞变异型 NSCHL: 类似反应性病变,有大量成纤维细胞和组织细胞,肿瘤细胞稀少,免疫组化 CD30 和 PAX5 有助诊断。

免疫组织化学染色:
CD30+(>95%),CD15+ (70-80%),PAX5+(弱),MUM-1+,CD20-/+, OCT2-/+,BOB1-,EBER-/+,CD79a- ,CD45-,EMA-,ALK-。
鉴别诊断:
- 原发性纵隔(胸腺)大 B 细胞淋巴瘤 (PMLBCL):通常见于年轻女性,前上纵隔快速生长肿块。肿瘤细胞弥漫增生,胞浆常淡染或透明。背景纤维化使瘤细胞分割区块化,但不形成结节。表达泛 B 细胞抗原如 CD20. CD79a、PAX5,LCA。 大多数 CD30 阳性,但为局灶性或较弱,且 CD15 阴性。多数 CD23+。
- 弥漫性大 B 细胞淋巴瘤 (DLBCL, NOS):肿瘤呈现弥漫生长,细胞形态类似中心母细胞或免疫母细胞。但有的亚型(间变型),细胞核大、多形,可类似 HRS 细胞。泛 B 细胞抗原和 LCA 阳性,CD10 和 Bcl-6 常阳性,CD30 可以弱阳性或局灶阳性,CD15 阴性。
- 间变性大细胞淋巴瘤 (ALCL):大型肿瘤细胞弥漫增生,可发现“标志性细胞”(偏心马蹄形或肾形核)。CD30 均匀强阳性(胞膜和 Golgi 区染色),CD15 阴性,T 细胞相关抗原阳性(如 CD4),EMA 和细胞毒标记常阳性, ALK+/-。B 细胞抗原阴性。
- 结节性淋巴细胞为主型霍奇金淋巴瘤 (NLPHL): 结节由反应性小 B 细胞组成, 滤泡网状结构保存(CD21+)。可有上皮样组织细胞,散在或小聚集,但无或很少其它炎性细胞。散在典型的 LP 细胞,其周围环绕以 T 细胞(CD3+/CD4+/PD1+),LP 细胞表达 CD20. CD79a、PAX5,但 CD30 阴性或偶尔弱阳性,一般不表达 CD15。
- 淋巴细胞丰富型经典霍奇金淋巴瘤 (TRCHL):常为结节状类,但结节主要由套区构成,并不时见到生发中心。典型的 HRS 细胞散在套区结节中,其他炎性细胞罕见。
- T 细胞/组织细胞丰富型大 B 细胞淋巴瘤 (THRLBCL):淋巴结正常结构完全破坏,呈现弥漫模式。在小淋巴细胞和组织细胞及其它炎性细胞背景下,见散在不典型大细胞(<10%)。大细胞形态可类似中心母细胞、免疫母细胞、LP 细胞或霍奇金细胞。大细胞表达全 B 细胞抗原,如 CD20. CD79a 和 PAX5,通常不表达 CD30(少数病例或有较弱或部分细胞表达),不表达 CD15; EBER/EBV 一般也阴性。
- 灰区淋巴瘤 :主要见于年轻成人男性,表现为纵隔肿块。肿瘤形态学和免疫学特征介于弥漫大 B 细胞淋巴瘤和经典霍奇金淋巴瘤之间。
- 外周 T 细胞淋巴瘤,非特指型 (PTCL,NOS):肿瘤细胞呈弥漫增生,常混有炎性背景细胞,有时可见很多 HRS 样细胞,且表达 CD30,但肿瘤细胞同时表达 CD3 等 T 细胞抗原,一般不表达 CD15,PAX5 阴性。分子检测有克隆性 TCR 基因重组。
- 传染性单核细胞增多症(IM) :多见于 15-25 岁。淋巴结结构常部分消失伴局灶坏死,可见残留反应性滤泡。增生的副皮质区或滤泡间区由大小不等的反应性细胞组成,常有浆细胞样分化, 有时可见大量免疫母细胞,或有局部散在 HRS 样细胞。HRS 样细胞可弱表达 CD30,但 CD15 阴性。EBER-ish 可见大量阳性细胞,多为小细胞或大小不等细胞。血清学检测可证实新近 EBV 感染。
预后:
预后总体较其它各型 CHL 好。
